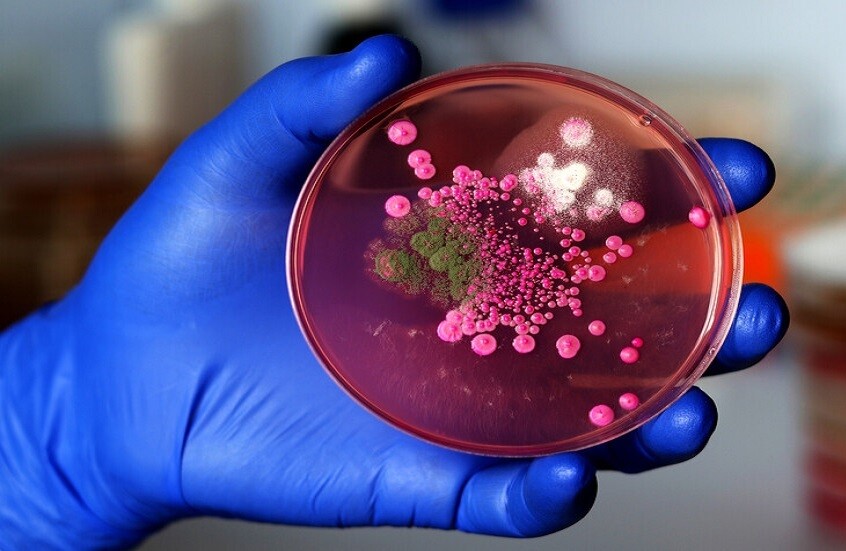
نوع جديد من الفطريات يهاجم الدماغ البشري!

Stories
-
90 دقيقة
RT STORIES
صفقة الموسم.. الاتحاد السعودي يقدم عرضا خرافيا لضم أحد أبرز نجوم برشلونة
#اسأل_أكثر #Question_MoreRT STORIES
محمد صلاح ينفرد برقم تاريخي في "البريمير ليغ".. فيديو
#اسأل_أكثر #Question_MoreRT STORIES
برشلونة ينجز مهمته أمام مضيفه إلتشي (فيديو)
#اسأل_أكثر #Question_MoreRT STORIES
ليفربول يقلب الطاولة على ضيفه نيوكاسل (فيديو)
#اسأل_أكثر #Question_MoreRT STORIES
شاهد.. هدف حسم "الموقعة" المغربية الجزائرية في دوري أبطال إفريقيا
#اسأل_أكثر #Question_MoreRT STORIES
أتلتيكو مدريد يعلن نقل مهاجم النرويجي سورلوث من الملعب إلى المستشفى مباشرة بسبب إصابة خطيرة (فيديو)
#اسأل_أكثر #Question_More
90 دقيقة
-
واشنطن تحشد لضرب إيران
RT STORIES
ترامب: محادثات جادة مع إيران.. وسفن حربية كبيرة تبحر باتجاهها
#اسأل_أكثر #Question_MoreRT STORIES
إيران تعد ملاجئ لـ 2.5 مليون من سكان طهران
#اسأل_أكثر #Question_MoreRT STORIES
الرئاسة المصرية: السيسي يجري اتصالا مع بزشكيان بشأن تجنب التصعيد الأمريكي الإيراني في المنطقة
#اسأل_أكثر #Question_MoreRT STORIES
بزشكيان: الحرب ليست في مصلحة أي طرف والتهديد والقوة لن يجبرا إيران على التفاوض
#اسأل_أكثر #Question_MoreRT STORIES
الخارجية القطرية: رئيس الوزراء بحث في طهران مع لاريجاني جهود خفض التصعيد في المنطقة
#اسأل_أكثر #Question_MoreRT STORIES
مسؤول سعودي لـ"الشرق الأوسط": لا تغيير في موقف المملكة.. ونرفض استخدام أجوائنا أو أراضينا ضد إيران
#اسأل_أكثر #Question_More
واشنطن تحشد لضرب إيران
-
التطورات الميدانية شمال شرق سوريا
RT STORIES
الشرع يبحث مع ماكرون دعم سوريا في مسار الاستقرار وإعادة الإعمار والاتفاق مع "قسد"
#اسأل_أكثر #Question_MoreRT STORIES
الشرع يبحث مع بارزاني اتفاق وقف إطلاق النار والتطورات الأخيرة في سوريا
#اسأل_أكثر #Question_MoreRT STORIES
غوتيريش يناشد الحكومة السورية و"قسد" تنفيذ إدماج شمال شرق سوريا بشكل سلمي
#اسأل_أكثر #Question_MoreRT STORIES
مظلوم عبدي: وقف إطلاق النار هو جوهر الاتفاق مع دمشق واندماج القوات سيتم بشكل منظم
#اسأل_أكثر #Question_MoreRT STORIES
اتفاق دمشق و"قسد".. الحكومة السورية تعين قائدا جديدا للأمن في الحسكة (صورة)
#اسأل_أكثر #Question_MoreRT STORIES
المبعوث باراك: الاتفاق بين دمشق و"قسد" محطة تاريخية نحو المصالحة الوطنية والوحدة والاستقرار
#اسأل_أكثر #Question_More
التطورات الميدانية شمال شرق سوريا
-
العملية العسكرية الروسية في أوكرانيا
RT STORIES
إعلام غربي: توقف المترو في كييف وخاركوف.. نظام الطاقة الأوكراني على حافة الانهيار
#اسأل_أكثر #Question_MoreRT STORIES
تاس: اجتماع أبوظبي بشأن أوكرانيا قائم في موعده غدا ولم يتم إلغاؤه
#اسأل_أكثر #Question_MoreRT STORIES
ويتكوف: مبعوث الرئيس الروسي عقد اجتماعات مثمرة وبناءة في فلوريدا بشأن تسوية الصراع الأوكراني
#اسأل_أكثر #Question_MoreRT STORIES
زيلينسكي: ننتظر اجتماعات جديدة لتسوية الأزمة الأسبوع المقبل
#اسأل_أكثر #Question_MoreRT STORIES
إحصائية لـ"تاس" تكشف خسائر قوات كييف البشرية خلال شهر يناير الفائت
#اسأل_أكثر #Question_MoreRT STORIES
المندوب الأمريكي لدى الناتو: اتفاق السلام خطوة أولى فقط نحو حل الأزمة الأوكرانية
#اسأل_أكثر #Question_More
العملية العسكرية الروسية في أوكرانيا
-
فيديوهات
RT STORIES
"حياة العرب مهمة".. مظاهرة حاشدة في تل أبيب ضد الجريمة في المجتمع العربي
#اسأل_أكثر #Question_MoreRT STORIES
آثار انفجار بمبنى سكني في بندر عباس جنوبي إيران
#اسأل_أكثر #Question_MoreRT STORIES
مبعوث الرئيس الروسي للتسوية الأوكرانية يتوجه لإجراء محادثات مع الوفد الأمريكي في ميامي
#اسأل_أكثر #Question_MoreRT STORIES
قصف إسرائيلي يستهدف خيام النازحين في مواصي خان يونس
#اسأل_أكثر #Question_MoreRT STORIES
الفيضانات تغمر مدينة القصر الكبير شمال المغرب
#اسأل_أكثر #Question_MoreRT STORIES
أعمدة الضوء النادرة تزين سماء بطرسبورغ
#اسأل_أكثر #Question_More
فيديوهات
اكتشاف "مفتاح إعادة ترتيب الذكريات" في الدماغ!
كشفت دراسة حديثة عن وظيفة جديدة مذهلة لمنطقة صغيرة في الدماغ تُعرف باسم "البقعة الزرقاء"، تعمل كـ"زر فصل" بين الذكريات المتتالية، مما يساعد الدماغ على تنظيم الأحداث كذكريات منفصلة.
وأشار معدّو الدراسة من جامعة كاليفورنيا في لوس أنجلوس وجامعة كولومبيا إلى أن "البقعة الزرقاء" هي مجموعة من الخلايا العصبية في جذع الدماغ، معروفة بدورها في اليقظة والانتباه، لكن هناك فرضية جديدة تشير إلى أنها قد تعمل كـ"زر فاصل" يفصل بين أجزاء التجارب المختلفة أثناء تخزين الذكريات، تماما كما تفصل الفصول بين أجزاء الكتاب.
ولاختبار هذه الفرضية، أجرى العلماء تجربة على 36 متطوعا، حيث شاهد المشاركون سلسلة من الصور المحايدة أثناء تنفيذ مهمة محددة. وقبل عرض كل صورة، كانوا يسمعون نغمة صوتية في الأذن اليمنى أو اليسرى، لتحديد اليد التي يجب استخدامها عند الإجابة عن سؤال يتعلق بحجم الشيء في الصورة.
ولم تُستخدم هذه الأصوات للإشارة فقط، بل أيضا لخلق إحساس بـ"السياق": إذ شكّلت سلسلة النغمات المتشابهة شعورا بالاستمرارية، بينما مثّلت التغييرات في النغمة أو في الجهة (يمين/يسار) "حدودا للأحداث". وفي هذه اللحظات تحديدا، كان الدماغ يقرر أن ذكرى معينة انتهت، لتبدأ أخرى جديدة.
نوع جديد من الفطريات يهاجم الدماغ البشري!
ووجد الباحثون أن نشاط "البقعة الزرقاء" يزداد بشكل ملحوظ عند حدود أحداث محددة مثل تغيّر النغمة أو الجهة. والأهم من ذلك أن هذه الذروات في النشاط تزامنت مع ضعف في تذكّر ترتيب مؤشرات التنبيه، ما يشير بقوة إلى أن الدماغ يقوم بتقسيم الانطباعات إلى أجزاء منفصلة بدلا من ربطها في تدفّق واحد مستمر.
كما أظهر تحليل البيانات أن ذروات نشاط "البقعة الزرقاء" تؤثّر مباشرة على منطقة الحُصين، وهي بنية دماغية رئيسية مسؤولة عن تكوين الذاكرة العرضية. وقد تبيّن للعلماء أن نشاط "البقعة الزرقاء" يُعيد ضبط عمل جزء من الحُصين يُسمّى التلفيف المسنّن، مما يساعد الدماغ على تمييز الأحداث المتشابهة وتشفيرها كذكريات مستقلة.
وكشفت الدراسة أيضا أن الأشخاص الذين يعانون من فرط النشاط المزمن في منطقة "البقعة الزرقاء"، لديهم حساسية أقل لحدود الأحداث. وبمعنى آخر، إذا كان نظام الإنذار في الدماغ يعمل في وضع "القلق الدائم"، فإنه يصبح أقل قدرة على الاستجابة للتغييرات المهمة فعلا في البيئة.
وصرّح ديفيد كليفت، الباحث الرئيسي من جامعة كاليفورنيا في لوس أنجلوس، موضحا جوهر الاكتشاف:
"الحياة تتدفق باستمرار، ولكن لكي نفهمها، نقسمها إلى فصول. نحن نتذكر الماضي ليس كتيار متواصل، بل كحلقات منفصلة. لذا أردنا نحن وزملاؤنا أن نفهم كيف يحوّل الدماغ هذا التدفق إلى فصول منفصلة مكرّسة لأحداث محددة".
وبعد هذه النتائج، يتطلّع العلماء إلى استكشاف إمكانية تنظيم مستوى تنبيه "البقعة الزرقاء" في الدماغ من خلال وسائل مثل تمارين التنفّس، والتأمل، أو الأدوية، لمعرفة ما إذا كان بالإمكان التأثير على كيفية فصل الذكريات. وقد يفتح ذلك الباب أمام تطبيقات علاجية مهمة في التعامل مع اضطرابات الذاكرة والخرف في المستقبل.
المصدر: mail.ru
إقرأ المزيد
كيف يفسر الدماغ بعض الروائح كنكهات حقيقية؟
توصل فريق من علماء معهد كارولينسكا في السويد إلى أن الدماغ يعالج بعض الروائح كما لو كانت مذاقا حقيقيا، موضحا سبب شعورنا بالحلاوة في المشروبات المنكهة الخالية من السكر.
"مناعة معرفية" تبنيها الموسيقى ضد الشيخوخة
أثبتت دراسة جديدة أن ممارسة العزف على آلة موسيقية لا تقتصر على تنمية المهارات الفنية فحسب، بل تشكل وسيلة فعالة لحماية الدماغ من الشيخوخة وتبني "مناعة معرفية" تدوم مدى الحياة.
طريقة روسية جديدة لعلاج ألزهايمر
أعلنت وزارة التعليم الروسية أن علماء وباحثين من معهد النظم الطبية الحيوية بجامعة البوليتيكنيك في بطرسبورغ اكتشفوا طريقة جديدة لعلاج مرض ألزهايمر.
فاكهة صيفية تعزز صحة الدماغ وتحمينا من الخرف
أظهرت دراسات أجراها علماء من بريطانيا أن تناول الكرز يساعد على محاربة بعض الأمراض المرتبطة بالشيخوخة، مثل الخرف.
ماذا يحدث في الدماغ عند تعلم شيء جديد؟
يتعلم الدماغ البشري بسرعة من التجارب ذات المغزى، ويبقي ذكرياتها حية لفترة طويلة، بينما يميل إلى نسيان التفاصيل اليومية الأقل أهمية.
دراسة تحذّر من ظاهرة صحية خطيرة مرتبطة بعطل نهاية الأسبوع
حذّرت دراسة طبية حديثة من أن مشكلات انقطاع التنفس أثناء النوم تزداد بشكل ملحوظ لدى الكثيرين خلال عطلة نهاية الأسبوع.
مفتاح جديد لمحاربة السمنة من باب الدماغ
ذكرت مجلة Nature Communications أن باحثين فرنسيين تمكنوا من اكتشاف طريقة جديدة لمحاربة السمنة.
كيف يعزز الإقلاع عن التدخين رحلة التعافي من الإدمان؟
أظهر علماء المعاهد الوطنية الأمريكية للصحة (NIH) أن الإقلاع عن التدخين يعزز التعافي من اضطرابات تعاطي المخدرات لدى البالغين الذين يعانون من إدمان الكحول أو المخدرات الأخرى.
حينما تفشل الموسيقى في إمتاع الدماغ.. دراسة تكشف اللغز
كشفت دراسة علمية حديثة عن السبب الكامن وراء عدم حب بعض الأشخاص للاستماع للموسيقى.
التعليقات